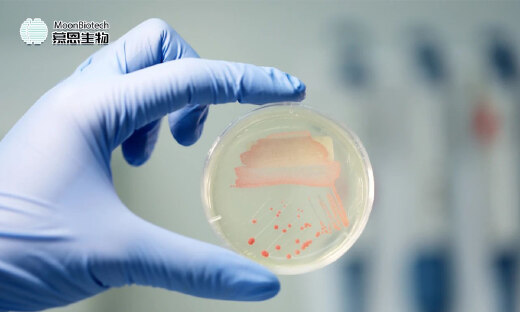
国投聚力独家投资，慕恩生物完成3亿元C+轮融资

# 聚合阅读 #
慕恩生物相关的文章共2篇
聚合所有猎云网 慕恩生物 相关的文章,为你持续提供跟踪报道
热门文章
-

红杉阿里押注的AI独角兽,18亿拿下一家上市公司
2025-12-12 -

立冬以来最大规模降雪来袭,美团:用户可免费体验“1对1急送”服务
2025-12-12 -

打造数字新基建,PingPong全球综合管理方案赋能连锁品牌加速出海
2025-12-12